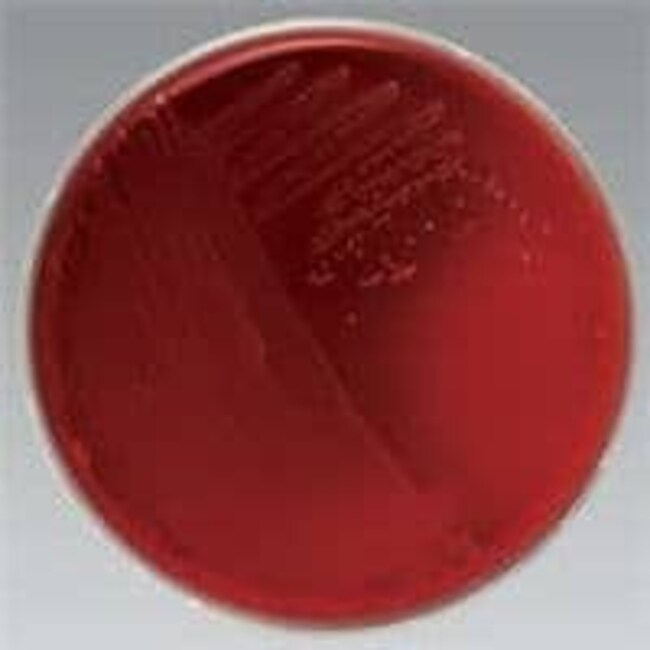
Remel™ 霉菌抑制琼脂(含氯霉素)

Search
Search
| 货号 | 数量 | 产品规格 |
|---|---|---|
| R08410 | 100 支/包 | 20mm x 113mm 管 |
Thermo Scientific™ Remel 霉菌抑制琼脂(含氯霉素)主要用于选择性分离荚膜组织胞浆菌、皮肤真菌和其他病原真菌。
Inhibitory Mold Agar primarily supports isolation and cultivation of dermatophytes and other pathogenic fungi. Inhibitory Mold Agar contains casein and meat peptones that supply nitrogenous compounds, amino acids, and peptides necessary for the growth of fungi. Dextrose, starch, and dextrin are ready sources of energy. Sodium chloride and metallic salts are essential electrolytes that help to maintains osmotic equilibrium. Yeast extract is a source of vitamins.